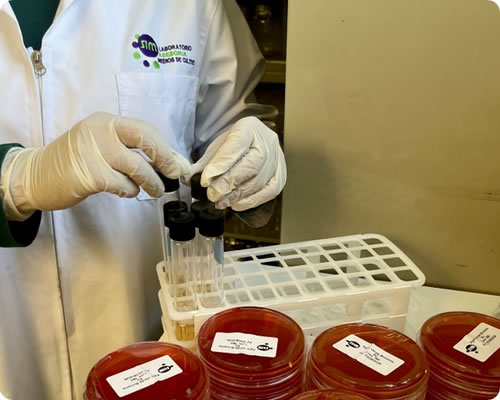

Somos un laboratorio industrial que ofrece servicios de análisis a la industria agropecuaria, alimentaria y farmacéutica desde el año 2000.
Contamos con la infraestructura y recurso humano capacitados para cumplir con la misión designada bajo la supervisión profesional.
Nuestros análisis están acreditados en la norma ISO 17025:2017 OGA-LE-045-11